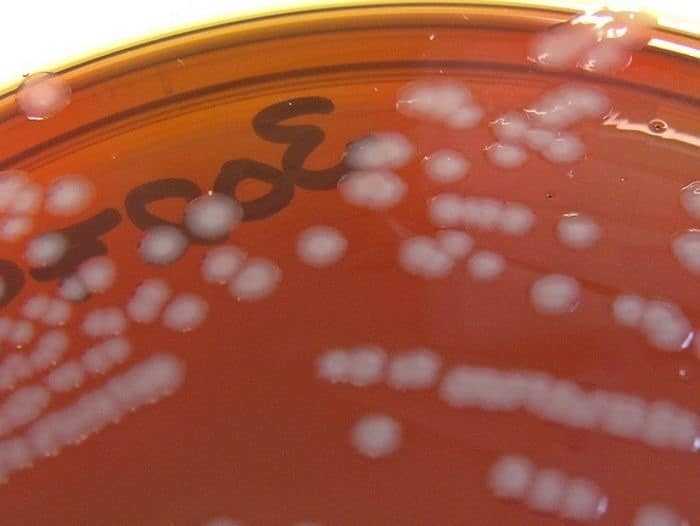
حالة من الهلع في الأوساط الطبية بعد الكشف عن مصاب بالسيلان

حالة من الهلع في الأوساط الطبية بعد الكشف عن مصاب بالسيلان
قد يكون مقبولا أن تفزع عند إصابتك بمرض معين، ولكن كيف يكون شعورك عندما يفزع طبيبك عند علمه بمرضك! إنه لأمر مقلق للغاية ما تم تشخيصه لرجل في المملكة المتحدة، فقد تعرض لعدوى السيلان المقاومة للعلاج بشكل كبير لدرجة أنه أفزع أطباءه.
ويُعزى هذا الفزع، لأن السيلان من الأمراض التي لا يجب أن تترك دون علاج. لكن هناك سبب آخر، فهذه الحالة هي نذير أزمة تلوح في الأفق.
وينتج السيلان بسبب عدوى بكتيرية، يمكن علاجها عادة باستخدام المضادات الحيوية. ولكن ومع مرور الوقت، نتيجة الاستخدام الخاطئ للمضادات الحيوية، فإن البكتريا قد طورت نوعا من المقاومة لهذه الأدوية. كما يصنف على أنه واحد من أكثر الأمراض شيوعًا في العالم والتي تنتقل عن طريق الاتصال الجنسي، حيث يوجد 78 مليون حالة جديدة كل عام.
وهناك ما يقرب من 30 في المئة من حالات العدوي بالسيلان تقاوم مضاد حيوي واحد على الأقل، وذلك وفقاً لمراكز السيطرة على الأمراض والوقاية منها (CDC).
لقد عرفنا أن هذا الخطر قادم، ففي عام 2017، أثارت منظمة الصحة العالمية إنذارًا عالميًا حول الانتشار المتزايد للبكتريا المقاومة للمضادات الحيوية الأقدم والأرخص. وقالت منظمة الأمم المتحدة في بيان أنه في بعض الدول التي تتمتع بنظم مراقبة متطورة لاستخدام الأدوية، وُجدت حالات مقاومة لجميع المضادات الحيوية المعروفة.
لكن هذه الحالة هي الأولى من نوعها، عندما قام المصاب بزيارة عيادة الطبيب في وقت سابق من هذا العام، ومن ثم خضع للعلاج باستخدام مزيج من اثنين من المضادات الحيوية _الأزيثروميسين والسيفترياكسون، وهي مضادات معروفة بفعاليتها في التخلص من المرض.
ولكن بعد فشل هذا المزيج في القضاء على العدوى، يتم الآن علاج المريض باستخدام مضاد حيوي أقوى يسمى الإِرتابينيم (ertapenem) عن طريق الحقن، وسيتم فحصه مرة أخرى خلال الشهر المقبل، وفقا لتقرير هيئة الصحة العامة البريطانية (PHE).
وطبقا لما نشرته صحيفة الغارديان، كشفت هيئة الصحة العامة البريطانية (PHE) في المملكة المتحدة أن المصاب بهذه السلالة شديدة المقاومة للمضادات الحيوية متزوج، ولكنه ربما أصيب أثناء رحلة في جنوب شرق آسيا، وتقوم السلطات حاليا بتعقب شركاء الرجل لمحاولة احتواء انتشار المرض.
يقول تيودورا واي _خبير في مجال الصحة الإنجابية في منظمة الصحة العالمية: “قد تكون هذه الحالات مجرد قمة جبل الجليد، لأن أنظمة التشخيص والإبلاغ عن حالات العدوى المقاومة، غير متطورة في البلدان المنخفضة الدخل والتي يشيع فيها مرض السيلان بدرجة كبيرة في الواقع”.
ونحن بالفعل بدأنا نشعر بذلك، فهذه البكتريا المقاومة للمضاد الحيوية تودي بحياة ما يصل إلى 50 ألف شخص كل عام في أوروبا والولايات المتحدة وحدهما، وحوالي 700 ألف شخص على الأقل كل عام على مستوى العالم.
ولكن ما الذي يجعل حالة السيلان هذه مميزة ومفزعة؟ حتى الآن، فقد قاومت هذه العدوى كل العلاجات التي كانت تعتبر في السابق فعالة للغاية. وحاليا يعالج الأطباء المريض بمضادات حيوية أكثر قوة على أمل أن ينجحوا في النهاية.
وإلى أن تتوفر لدينا علاجات أكثر فعالية لمرض السيلان وغيره من أنواع العدوى المقاومة للمضادات الحيوية، فإن الطريقة الوحيدة لتجنب الإصابة بالعدوى المنقولة جنسياً المقاومة للعلاج تكمن في اتباع وسائل العلاقة الجنسية الآمنة.


